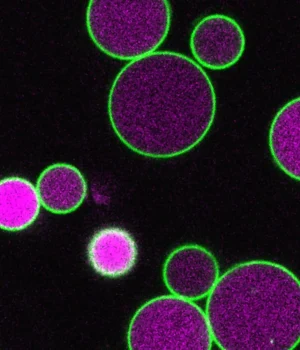

As plantas usam a fotossíntese para produzir energia durante a maior parte de suas vidas. No entanto, nos estágios iniciais, após uma semente começar a germinar, ela ainda não consegue captar luz. Durante esta breve mas crítica janela, eles dependem de ácidos graxos armazenados. Para decompor estes ácidos gordos, as células vegetais utilizam uma estrutura especial conhecida como peroxissoma, um compartimento ligado à membrana também encontrado nas células humanas. Devido ao seu tamanho e visibilidade, as células vegetais servem como um sistema útil para estudar o funcionamento dos peroxissomos.
“A planta que usamos, Arabidopsis, tem células grandes e peroxissomos tão grandes que podemos ver seu interior com um microscópio óptico”, disse Bonnie Bartel, professora de biociências Ralph e Dorothy Looney. “Os peroxissomos tornam-se maiores durante o crescimento da semente à muda, quando a planta depende de ácidos graxos para obter energia, antes de retornar ao seu tamanho normal quando a planta pode fotossintetizar.”
A proteína PEX11 ajuda a regular o tamanho do peroxissomo
A equipe de Bartel se concentrou nesses peroxissomos aumentados, especificamente em uma proteína chamada PEX11. Os cientistas sabem há muito tempo que o PEX11 desempenha um papel na ajuda à divisão dos peroxissomos. Numa nova investigação publicada na Nature Communications, a equipa descobriu que esta proteína ajuda a controlar a forma como os peroxissomas se expandem e contraem durante o desenvolvimento inicial das plantas.
“Os peroxissomos estão envolvidos em algumas doenças humanas e são usados em bioengenharia”, disse Nathan Tharp, primeiro autor do artigo e estudante de pós-graduação da Rice. “No entanto, eles podem ser bastante difíceis de estudar.”
Usando CRISPR para estudar uma proteína complexa
Uma técnica comum para compreender uma proteína é inativar o gene responsável por produzi-la e observar os efeitos. Neste caso, a situação era mais complicada. PEX11 é produzido por cinco genes diferentes. Interromper apenas um deles teve pouco efeito, mas remover todos os cinco matou a planta. Isso dificultou a identificação da função da proteína.
Para contornar esse problema, Tharp usou técnicas avançadas de CRISPR para desabilitar seletivamente diferentes combinações de cinco genes.
“Consegui usar avanços recentes no CRISPR e quebrar combinações específicas de cinco genes”, disse Tharp, que recentemente defendeu sua tese. “Só então descobrimos que o PEX11 está claramente envolvido na regulação do crescimento do peroxissomo desde a fase de semente até a muda.”
Peroxissomos gigantes expressam mecanismos reguladores do crescimento
Tharp criou dois tipos de plantas mutantes, cada uma sem um conjunto específico de genes PEX11. Em ambos os casos, os peroxissomos se expandem conforme esperado, desde a fase de semente até a fase de plântula. No entanto, em vez de voltarem ao tamanho normal, alguns continuam a crescer muito além da faixa normal. Em casos extremos, os peroxissomos se estendem de uma extremidade à outra da célula.
Essas células mutantes também não possuíam vesículas, pequenos compartimentos ligados à membrana que normalmente se formam dentro dos peroxissomos durante o processamento de ácidos graxos. Em condições normais, essas vesículas se desenvolvem à medida que os peroxissomos crescem e parecem desprender porções de sua membrana externa.
“As vesículas podem ajudar a regular o crescimento dos peroxissomos à medida que formam fragmentos de membrana”, disse Tharp. “Em nossos mutantes PEX11, essas vesículas não se formam ou são anormalmente pequenas e raras, e por isso vemos esses peroxissomos gigantes, muito maiores que o normal”.
As descobertas vão além das plantas para outras espécies
Embora a pesquisa se concentrasse nas plantas, Tharp queria saber se o mesmo processo poderia existir em outros organismos. Para testar esta ideia, ele introduziu versões de levedura de uma proteína chamada Pex11 em células vegetais mutantes.
“Colocamos a levedura Pex11 em nossas células vegetais mutantes para ver se ela poderia restaurar os peroxissomos ao normal”, disse Tharp. “E aconteceu.”
Este resultado sugere que o Pex11 funciona de forma semelhante nas leveduras e nas plantas, apesar da grande distância evolutiva entre elas. Por esta razão, as proteínas podem desempenhar papéis comparáveis em outros tipos de células, incluindo células humanas.
“O fato de que esta proteína desempenha funções semelhantes nas células de leveduras e vegetais sugere que pode ser uma proteína altamente conservada”, disse Bartel. “Nossas descobertas em plantas, neste modelo relativamente simples de estudar, podem, portanto, ser aplicáveis a células humanas e células usadas para bioengenharia”.